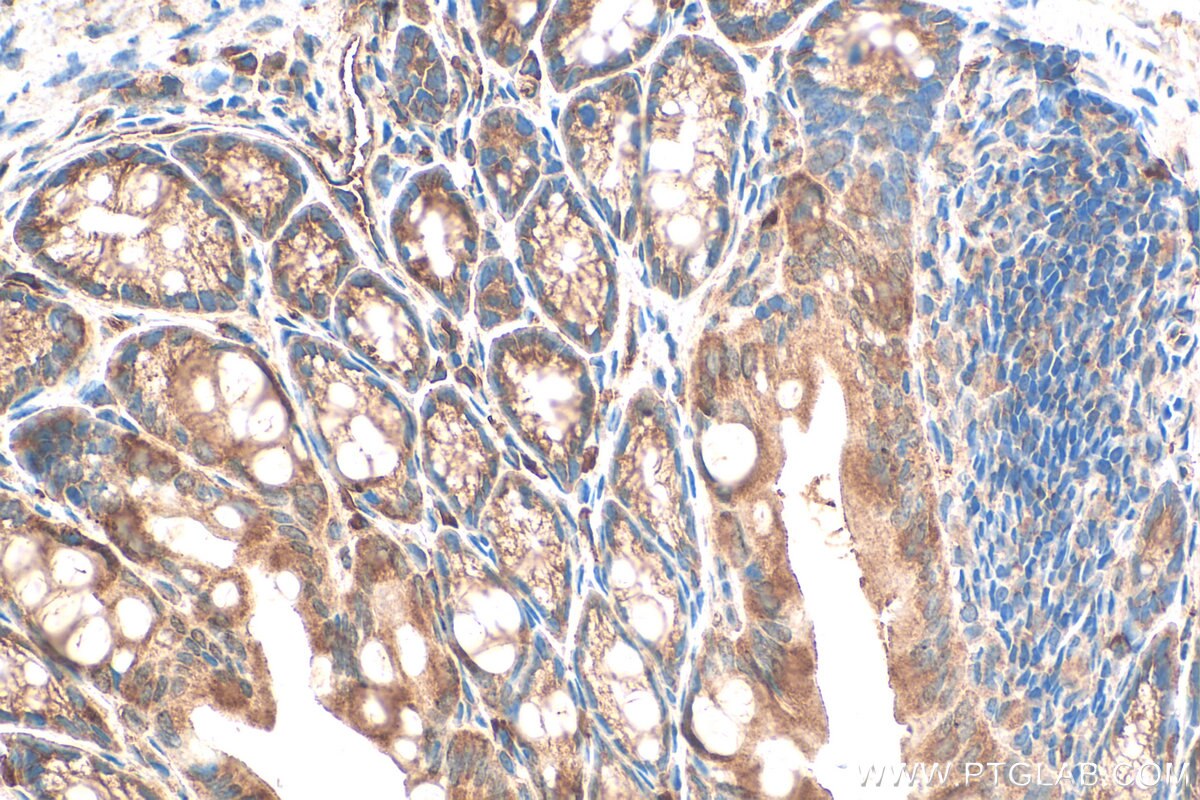
Immunohistochemical analysis of paraffin-embedded mouse colon tissue slide using 20729-1-AP (ITPR3 antibody) at dilution of 1:400 (under 40x lens). Heat mediated antigen retrieval with Tris-EDTA buffer (pH 9.0). Immunohistochemistry (IHC) staining of mouse colon tissue using ITPR3 Polyclonal antibody (20729-1-AP)

Tested Applications
| Positive WB detected in | HeLa cells |
| Positive IHC detected in | mouse colon tissue, mouse cerebellum tissue, mouse small intestine tissue Note: suggested antigen retrieval with TE buffer pH 9.0; (*) Alternatively, antigen retrieval may be performed with citrate buffer pH 6.0 |
Recommended dilution
| Application | Dilution |
|---|---|
| Western Blot (WB) | WB : 1:500-1:1000 |
| Immunohistochemistry (IHC) | IHC : 1:200-1:800 |
| It is recommended that this reagent should be titrated in each testing system to obtain optimal results. | |
| Sample-dependent, Check data in validation data gallery. | |
Published Applications
| WB | See 6 publications below |
Product Information
20729-1-AP targets ITPR3 in WB, IHC, ELISA applications and shows reactivity with human, mouse samples.
| Tested Reactivity | human, mouse |
| Cited Reactivity | human, mouse, rat |
| Host / Isotype | Rabbit / IgG |
| Class | Polyclonal |
| Type | Antibody |
| Immunogen |
Peptide Predict reactive species |
| Full Name | inositol 1,4,5-triphosphate receptor, type 3 |
| Calculated Molecular Weight | 304 kDa |
| Observed Molecular Weight | 250-300 kDa |
| GenBank Accession Number | NM_002224 |
| Gene Symbol | ITPR3 |
| Gene ID (NCBI) | 3710 |
| RRID | AB_3669343 |
| Conjugate | Unconjugated |
| Form | Liquid |
| Purification Method | Antigen affinity purification |
| UNIPROT ID | Q14573 |
| Storage Buffer | PBS with 0.02% sodium azide and 50% glycerol, pH 7.3. |
| Storage Conditions | Store at -20°C. Stable for one year after shipment. Aliquoting is unnecessary for -20oC storage. 20ul sizes contain 0.1% BSA. |
Background Information
ITPRs family have three members: ITPR1, ITPR2 and ITPR3. For ITPR3, it is associated with cervical squamous cell carcinoma, glioblastoma, cholangiocarcinoma and other cancers. Inositol 1,4, 5-triphosphate receptor type 3 (ITPR3) was found to be apical-located in bile duct cells, and disruption of lipid raft in the segregated bile duct unit (IBDU) redistributes ITPR3 and impairs Ca2+ waves. (PMID: 35580861, PMID:35852334)
Protocols
| Product Specific Protocols | |
|---|---|
| IHC protocol for ITPR3 antibody 20729-1-AP | Download protocol |
| WB protocol for ITPR3 antibody 20729-1-AP | Download protocol |
| Standard Protocols | |
|---|---|
| Click here to view our Standard Protocols |
Publications
| Species | Application | Title |
|---|---|---|
J Ethnopharmacol Zhizichi decoction alleviates depressive-like behaviors through modulating mitochondria-associated membrane via the IP3R3-GRP75-VDAC1 complex | ||
Mol Cell Endocrinol High glucose elevates intracellular calcium level and induces ferroptosis in glomerular endothelial cells through the miR-223-3p/ITPR3 pathway | ||
J Ethnopharmacol Combining metabolomics and network pharmacology to clarify the mechanism of Angelica sinensis-Sophora flavescens pills in treating atopic dermatitis through the sweet-bitter harmonization theory | ||
Ecotoxicol Environ Saf Protective role of RGS2 in PM2.5-induced ovarian injury in rats: Modulation of Gq/11 signaling to maintain granulosa cell [Ca2 + ]i stability | ||
Adv Sci (Weinh) Massage-Mimicking Nanosheets Mechanically Reorganize Inter-organelle Contacts to Restore Mitochondrial Functions in Parkinson's Disease | ||
Sci Rep Polydatin exerts therapeutic effects on myelodysplastic syndrome by inhibiting the protein expression of oncogenes via hypermethylation in vitro |